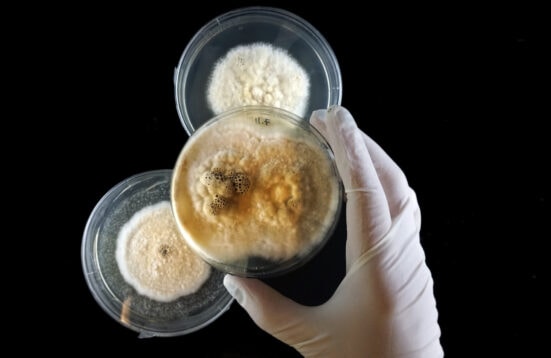

Co-Existences
On Human and Nonhuman Agents
Article | Regine Rapp

R. Rapp: Koexistenzen. Über menschliche und nicht-menschliche Akteur:innen [Co-Existences. On Human and Nonhuman Agents], in: Kunstforum International, Bd. 281, 04/2022, [syn]Zusammen [bios]Leben, S. 82 – 93.
Introduction | First paragraphs of the article
“The realisation that we always live in symbiosis, i.e. in a system of living beings of different species with physical contact,[i] has been intensively explored in recent artistic research in the hybrid arts.[ii] The Nonhuman Subjectivities concept takes up the idea of symbiosis and examines current artistic positions that place non-human organisms – animals, plants, fungi, microbes – at the centre of their exploration. The research project is directly linked to the research and exhibition series (2016-2019) of Art Laboratory Berlin.[iii] As different as their artistic strategies, formats and aesthetic criteria are, the artistic positions are united by an interest in concepts of the agency and sentience of nonhuman beings. This goes hand in hand with ideas of human-nonhuman forms of communication and a critical revision of definitions of intelligence, expanded by concepts of post-humanism and the material turn.[iv]
This article is accompanied by a direct critique of anthropocentrism. Central to this is the idea of a decentred repositioning of humans in a time in which the effects caused by humans on the environment are serious and often irreversible.[v] The awareness of constant interspecies connections is fundamental: ‘To be one is always to become with many.’[vi] In subsequent research projects at Art Laboratory Berlin, such as Mind the Fungi (2018-20), The Camille Diaries. New Artistic Positions on M/otherhood, Life and Care (2020) or Under the Viral Shadow. On Networks in the Age of Technoscience and Infection (2021), the idea of symbiosis is repeatedly at the centre of the debates. On the one hand, this is aimed at biopolitical aspects; on the other, it addresses the dichotomy of the technological and the biological.
The artistic positions presented below deal with different approaches and focal points of co-existences of human and non-human actors. […]”
[i] Lynn Margulis: Der symbiotische Planet, Frankfurt/Main 2017, p. 10 (The Symbiotic Planet, New York 1998).
[ii] Regine Rapp: „Hybrid Art“, in: Ronald Grätz/Maike Weißpflug (ed.): NaturKultur, Göttingen 2021, p. 74-81.
[iii] Nonhuman Agents in Art, Culture and Theory, interdisziplinary international conference, conceived and realised by Regine Rapp and Christian de Lutz, Art Laboratory Berlin, 24 – 26 November 2017. About the concept of the conference: “As a theoretical addition to our ongoing series Nonhuman Agents (June – December 2017) Art Laboratory Berlin – along with our partners, The Institute for Arts and Media, University of Potsdam – has brought together international artists, scholars, and scientists from different disciplines to discuss artistic, philosophical, ethical and scientific approaches to nonhuman agency. Previous positions from our Nonhuman Subjectivities series (2016-17) were also included.” (Rapp/de Lutz). The conference comprised 25 contributions by artists and scientists from the natural sciences and humanities (microbiology, botany and the arts, philosophy and history). All contributions were video-recorded and are available online: https://artlaboratory-berlin.org/publications/nonhuman-agents-in-art-culture-and/. The artists’ positions presented and researched in the years 2016 to 2019 are François-Joseph Lapointe, Saša Spača (with Mirjan Švagelj, Anil Podgornik), Tarsh Bates, Joana Ricou, Rachel Mayeri, Maja Smrekar, Brandon Ballengée, Katya Gardea Browne, Pinar Yoldas, Robertina Šebjanič, Alinta Krauth, Heather Barnett, Theresa Schubert, Margherita Pevere, Sarah Hermanutz, Alanna Lynch, Špela Petrič, Kat Austen, Mary Maggic, Fara Peluso, and Vivian Xu.
[iv] The theoretical basis for the concept of nonhuman subjectivities included the following publications: Donna J Haraway: When Species Meet, University of Minnesota Press 2008; Rosi Braidotti: On the Posthuman, Cambridge 2013; Grusin, Richard: The Nonhuman Turn, Minneapolis 2015; and John Gray: Straw Dogs. On Human and Other Animals, London 2002.
[v] It is not without reason that Richard Grusin refers in his foreword to The Nonhuman Turn to all the current disasters caused by humans and the need to address everything nonhuman: “Given that almost every problem of note that we face in the 21st century entails engagement with nonhumans – from climate change, drought and famine; to biotechnology, intellectual property, and privacy; to genocide, terrorism, and war – there seems no time like the present to turn our future attention, resources, and energy toward the nonhuman broadly understood.” Richard Grusin: The Nonhuman Turn, (see note 4), p. vii.
[vi] Donna J. Haraway: When Species meet (compare note 4), p. 4.
(English translation by the author)
Full articel accessible here:
https://artlaboratory-berlin.org/assets/pdf/281_KUNSTFORUM_International_Rapp_Koexistenzen-1.pdf
**********
In German (original language of the article):
“Die Erkenntnis, dass wir stets in Symbiose leben, also in einem System aus Lebewesen verschiedener Arten mit körperlichem Kontakt,[i] ist in der jüngsten künstlerischen Forschung der Hybrid Arts intensiv verarbeitet worden.[ii] Das Konzept Nonhuman Subjectivities greift den Symbiose-Gedanken auf und untersucht aktuelle künstlerische Positionen, die nichtmenschliche Organismen – Tiere, Pflanzen, Pilze, Mikroben – ins Zentrum ihrer Auseinandersetzung stellen. Das Forschungsprojekt steht in unmittelbarer Verbindung mit den Forschungs- und Ausstellungsreihen (2016–2019) von Art Laboratory Berlin.[iii] So unterschiedlich ihre künstlerischen Strategien, Formate und ästhetischen Kriterien auch sind, so vereint die künstlerischen Positionen das Interesse an Auffassungen von Handlungsfähigkeit und Empfindungsvermögen nichtmenschlicher Wesen. Damit gehen Ideen menschlich-nichtmenschlicher Kommunikationsformen sowie eine kritische Revision von Intelligenz-Definitionen einher, erweitert durch Konzepte des Posthumanismus und des Material Turn.[iv]
Der vorliegende Beitrag geht mit einer unmittelbaren Kritik am Anthropozentrismus einher. Zentral ist dabei die Idee einer dezentrierten Neupositionierung des Menschen in einer Zeit, in welcher die durch Menschen verursachten Auswirkungen auf die Umwelt gravierend und oftmals unumkehrbar sind.[v] Grundlegend ist die Bewusstwerdung steter zwischenartlicher Verbindungen: ‘To be one is always to become with many’.[vi] Auch in den darauf folgenden Forschungsprojekten bei Art Laboratory Berlin wie etwa Mind the Fungi (2018-20), The Camille Diaries. New Artistic Positions on M/otherhood, Life and Care (2020) oder Under the Viral Shadow. On Networks in the Age of Technoscience and Infection (2021) steht der Gedanke der Symbiose immer wieder stark im Zentrum der Auseinandersetzungen. Dieser zielt zum einen auf biopolitische Aspekte, zum anderen adressiert er die Dichotomie des Technologischen und Biologischen.
Die […] vorgestellten künstlerischen Positionen befassen sich mit unterschiedlichen Ansätzen und Schwerpunkten von Ko-Existenzen menschlicher und nicht-menschlicher Akteur:innen.”
[…]
[i] Lynn Margulis: Der symbiotische Planet, Frankfurt/Main 2017, p. 10 (The Symbiotic Planet, New York 1998).
[ii] Regine Rapp: „Hybrid Art“, in: Ronald Grätz/Maike Weißpflug (Hg.): NaturKultur, Göttingen 2021, p. 74-81.
[iii] Nonhuman Agents in Art, Culture and Theory, interdisziplinäre internationale Konferenz, konzipiert und realisiert von Regine Rapp und Christian de Lutz, Art Laboratory Berlin, 24.-26.11.2017. Zum Konzept der Konferenz: „Als theoretische Ergänzung zu unserer laufenden Reihe Nonhuman Agents (Juni–Dezember 2017) vereinte Art Laboratory Berlin – gemeinsam mit unseren Partnern, dem Institut für Kunst und Medien, Universität Potsdam – internationale Künstler:innen, Wissenschaftler:innen aus Natur- und Geisteswissenschaften verschiedener Disziplinen, um künstlerische, philosophische, ethische und naturwissenschaftliche Ansätze über nichtmenschliche Akteure zu diskutieren. Bisherige Positionen aus unserer Reihe Nonhuman Subjectivities (2016-17) wurden miteinbezogen.“ (Rapp/de Lutz, ebd.). Die Konferenz umfasste 25 Beiträge von Künstler:innen und Wissenschaftler:innen aus den Natur- und Geisteswissenschaften (Mikrobiologie, Botanik und Kunstwissenschaften, Philosophie und Geschichtswissenschaften). Alle Beiträge wurden per Video aufgezeichnet und sind online zugänglich: https://artlaboratory-berlin.org/de/publikationen/nonhuman-agents-in-art-culture-and/ (zuletzt aufgerufen: 3.1.2022). Die in den Jahren 2016 bis 2019 präsentierten und erforschten Künstler:innenpositionen sind: François-Joseph Lapointe, Saša Spača (mit Mirjan Švagelj, Anil Podgornik), Tarsh Bates, Joana Ricou, Rachel Mayeri, Maja Smrekar, Brandon Ballengée, Katya Gardea Browne, Pinar Yoldas, Robertina Šebjanič, Alinta Krauth, Heather Barnett, Theresa Schubert, Margherita Pevere, Sarah Hermanutz, Alanna Lynch, Špela Petrič, Kat Austen, Mary Maggic, Fara Peluso und Vivian Xu.
[iv] Als theoretische Grundlage für das Konzept Nonhuman Subjectivities waren u.a. folgende Publikationen wesentlich: Donna J Haraway: When Species Meet, University of Minnesota Press 2008; Rosi Braidotti: On the Posthuman; Cambridge 2013; Grusin, Richard: The Nonhuman Turn, Minneapolis 2015; sowie John Gray: Straw Dogs. On Human and Other Animals, London 2002.
[v] Nicht ohne Grund verweist Richard Grusin in seinem Vorwort von The Nonhuman Turn auf sämtliche durch den Menschen entstandene aktuelle Katastrophen und die Notwendigkeit, sich allem Nichtmenschlichen zuzuwenden: „Angesichts der Tatsache, dass fast jedes nennenswerte Problem, mit dem wir im einundzwanzigsten Jahrhundert konfrontiert sind, mit dem Umgang mit dem Nichtmenschlichen zu tun hat – vom Klimawandel, Dürre und Hungersnöten bis hin zu Biotechnologie, geistigem Eigentum und Privatsphäre; bis hin zu Völkermord, Terrorismus und Krieg – scheint es keine passendere Zeit als die der Gegenwart zu geben, um unsere zukünftige Aufmerksamkeit, unsere Ressourcen und unsere Energie auf das Nichtmenschliche im weitesten Sinne zu lenken.“ Vgl. Richard Grusin: The Nonhuman Turn, (wie Anm. 4), p. vii, Übersetzung der Autorin.
[vi] Donna J. Haraway: When Species meet (as note 4), p. 4.
Der gesamte Aufsatz ist hier einsehbar:
https://artlaboratory-berlin.org/assets/pdf/281_KUNSTFORUM_International_Rapp_Koexistenzen-1.pdf